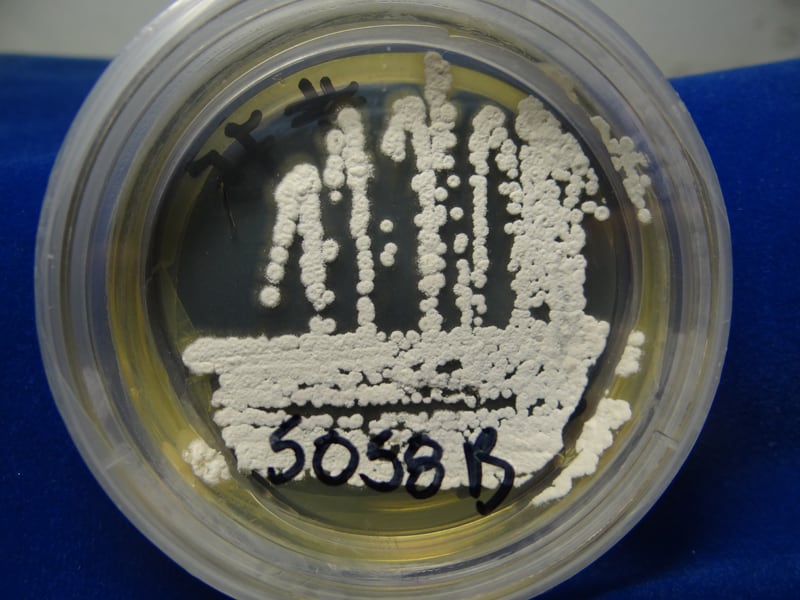

Un equipo de investigadores ticos y estadounidenses descubrió dos compuestos químicos en una muestra de suelo marino del país que poseen propiedades antibióticas, las cuales podrían derivar en nuevos fármacos para control de infecciones.
Se trata de compuestos denominados baulamicinas, bautizados así en honor a su lugar de origen: el Parque Nacional Marino Las Baulas, ubicado en Santa Cruz de Guanacaste.
El hallazgo lo realizaron n científicos del Instituto Nacional de Biodiversidad (INBio) y de la Universidad de Míchigan, Estados Unidos.
La investigación, que incluyó la recolección de muestras, cuenta con permisos tanto de la Comisión Nacional para la Gestión de la Biodiversidad de Costa Rica (Conagebio), como del Sistema Nacional de Áreas de Conservación (Sinac).
“La alta biodiversidad es un imán para la ciencia porque permite muchas opciones. En los últimos 20 años, la mitad de medicamentos aprobados en el mundo tuvieron origen en la naturaleza, aunque no son productos naturales per se ”, manifestó Allan Jiménez, coordinador de la Unidad de Bioprospección en el INBio.

Descubrimiento. El suelo marino fue recolectado a poca profundidad (a menos de 20 metros), en Playa Grande, una de las que forman el parque Las Baulas.
Los investigadores tomaron las muestras y las colocaron en placas de laboratorio, donde empezó a darse una intensa actividad microbiana.
En una de esas pruebas se identificó un microorganismo que resultó ser nuevo para la ciencia y que fue bautizado con el nombre de Streptomyces tempisquensis , en honor al Área de Conservación Tempisque (ACT).
“ Streptomyces es un género de bacterias. Antes se creía que eran hongos”, comentó Jiménez.
Luego, se sometió al microorganismo a procesos de fermentación. “Eso es ponerlo en un medio de cultivo que contiene azúcares y sales; es decir, se le da de comer para que comience a generar sustancias y ese metabolismo secundario es lo que a nosotros nos interesa”, explicó el científico.
Durante ese proceso, Streptomyces tempisquensis produjo dos tipos de baulamicinas (A y B), que también resultaron ser nuevas para la ciencia.
“Ya aislados en el laboratorio, estos compuestos demostraron tener una interesante actividad antibiótica de amplio espectro. Eso significa que atacan distintos tipos de infecciones, como las cutáneas, las de garganta y oídos, causadas por distintas bacterias”, detalló Jiménez.

Primera fase. Este hallazgo apenas constituye la primera fase de lo que podría ser un proceso de 25 años, que cerraría con un fármaco como último resultado.
“Esto está aún a nivel universitario de pruebas biológicas, pero en el futuro –y si se interesara alguna farmacéutica– podría convertirse en medicamento”, citó el investigador del INBio.
Esta etapa inicial ya consumió cuatro años, y la siguiente, de desarrollo de alguna medicina, se extendería por 20 más.
“Después del descubrimiento, lo que sigue es la optimización de la molécula. Se agarra esa molécula y se empiezan a hacer cambios químicos para reducir su toxicidad y aumentar su actividad.
”Se prueba en fases preclínicas (animales) y luego en clínicas (humanos). Aún habría un último paso, que es el seguimiento del medicamento una vez liberado al mercado”, indicó Jiménez.
Aunque su capacidad solo le permite al INBio hacerse cargo de la primera etapa, sí le daría seguimiento al resto de la investigación y su participación sería remunerada con el cobro de regalías por la venta del fármaco.
De ser así, el 50% de esas ganancias le corresponden al Ministerio de Ambiente (Minae) y el otro 50% iría a seguir financiando estudios en el INBio.
“Cuando el país haga las inversiones requeridas en ciencia y tecnología para desarrollar el producto hasta el final, pues ya no necesitaríamos a las farmacéuticas”, manifestó Randall García, director de INBio.
“Aun así, Costa Rica se destaca por tener el conocimiento y la experiencia para desarrollar esta primera etapa. Además, nosotros, como costarricenses, tenemos la gran ventaja de contar con un marco legal que regula este tipo de actividades”, añadió.